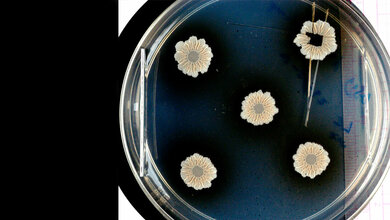
Das Foto zeigt Biofilme aus dem Wildtyp Bacillus subtilis.

Bakterien lieben feuchte Oberflächen. Haben sie sich dort erst einmal niedergelassen, leben sie nicht als Einzelgänger, sondern bilden größere Gemeinschaften, die mit einem Schutzfilm umgeben sind. Diese Biofilme findet man auf verschiedenen Oberflächen, etwa im Haushalt an Lichtschaltern, im Badezimmer, auf Spielzeug oder Tastaturen, an Einkaufswagen oder Bankautomaten, die viele Menschen mit ihren Händen berühren. Dies kann zu Kontaktinfektionen führen. Die Keime, beispielsweise der pathogene Keim Pseudomonas aeruginosa, sind oft hartnäckig und trotzen der körpereigenen Abwehr oder chemischen Bioziden. Aktuelle Forschungsansätze versuchen daher, die bakterielle Besiedlung von Materialoberflächen zu verhindern oder zumindest zu erschweren. Ein Team der Johannes Gutenberg-Universität Mainz (JGU) und der Bundesanstalt für Gewässerkunde (BfG) in Koblenz hat nun einen neuen Ansatz mithilfe von Cerdioxid-Nanopartikeln entwickelt.
Bakterien „mundtot“ machen
Für das Leben der Bakterien in Gemeinschaften ist es wichtig, dass sich die einzelnen Zellen „absprechen“. Die Kommunikation erfolgt nonverbal mit Hilfe von Signalmolekülen, die kontinuierlich an die Umgebung abgegeben werden, wobei je nach Bakterium unterschiedliche „Sprachen“ und „Dialekte“ vorkommen können. Mit steigender Bakterienkonzentration steigt auch die Konzentration der Signalmoleküle. So können Bakterien die Zahl anderer Bakterien in ihrer Umgebung erkennen und Prozesse aktivieren, welche die Bildung von Biofilmen ermöglichen.
Um die Besiedlung mit bakteriellen Biofilmen zu verhindern, verteidigen sich verschiedene Wirte mit einer Strategie, die die Bakterien durch eine enzymatische Veränderung der Signalmoleküle „mundtot“ macht. Dies erfolgt zum Beispiel mit Hilfe von Haloperoxidasen, einer Gruppe von Enzymen, die über eine komplexe Reaktionskette die Signalmoleküle halogenieren.
Diese veränderten Signalmoleküle besitzen eine ähnliche Struktur wie die Ausgangsmoleküle und können noch an Rezeptoren binden. Sie können aber nicht mehr die Prozessketten aktivieren, die zur Bildung von Biofilmen führen. Dieser Eingriff in die bakterielle Genregulation ist auch von pharmakologischem Interesse, denn pathogene Bakterien können sich durch die Bildung von Biofilmen dem Angriff der Immunabwehr oder der Wirkung von Antibiotika entziehen.
Nachahmung der Vorgänge
Diese Vorgänge ahmen die Mainzer und Koblenzer Forscher mit Nanopartikeln aus Cerdioxid (CeO2) nach. CeO2 Nanopartikel seien, so schreiben die Forscher und Forscherinnen, ein funktioneller Ersatz für Haloperoxidase-Enzyme. Die molekularen Mechanismen, die der Biofilmhemmung zugrunde liegen, sind jedoch im Detail schwer zu entschlüsseln, da in Bakterienkulturen nicht nur viele Konkurrenzreaktionen ablaufen, sondern neben den halogenierten Signalmolekülen auch massenhaft andere Biomoleküle vorhanden sind.
Die Kooperationspartner aus Mainz und Koblenz weisen die Enzym-analoge katalytische Beteiligung der CeO2-Nanopartikel über eine Analyse der Reaktionskaskade auf molekularer Ebene nach. Die halogenierten Signalmoleküle wurden zunächst in Modellreaktionen identifiziert. In Bakterienkulturen war ihr Nachweis zwar nicht direkt möglich, da die Produkte zu schnell abgebaut werden. Die chromatografische Aufarbeitung und massenspektrometrische Analyse zeigte aber völlig unerwartet die Bildung weiterer halogenierter Signalmoleküle aus der Familie der sogenannten Chinolone. Dies zeigt, dass die CeO2-Nanopartikel genau wie native Enzyme in biologische Prozesse eingreifen, indem sie Signalmoleküle verändern und inaktivieren.
Keine Gefahr der Resistenzbildung
„Cerdioxid ist ungiftig, chemisch sehr stabil und beispielsweise in modernen Abgaskatalysatoren von Fahrzeugen enthalten“, bemerkt Dr. Eva Pütz, die ihre Doktorarbeit auf diesem Projekt durchführte. Sie ist überzeugt, dass Cerdioxid eine praktikable und kostengünstige Alternative zu konventionellen Bioziden ist. „Eine praktische Anwendung unserer Befunde ist die Blockade des Bakterienwachstums und die Verhinderung bakterieller Infektionen. Die Chinolon-Signalmoleküle führen bei dem multiresistenten Bakterium Staphylococcus aureus zur Bildung kleiner Kolonievarianten, die diagnostisch oft nicht nachweisbar sind. Da die halogenierten Chinolon-Signalmoleküle die Koloniebildung unterdrücken, können zum Beispiel gefährliche Infektionen durch P. aeruginosa und S. aureus mithilfe von Lackdispersionen, in denen CeO2-Nanopartikel enthalten sind, verhindert werden“, fügt Dr. Athanasios Gazanis hinzu, der die mikrobiologischen Aspekte in seiner Doktorarbeit untersuchte.
Neue Generation von antibakteriellen Oberflächen?
„Wir haben hier eine umweltverträgliche Komponente für eine neue Generation von antibakteriellen Oberflächen, die das Verteidigungssystem der Natur nachahmen. Vor allem funktioniert es nicht nur im Labor, sondern auch im täglichen Gebrauch“, sagt Nils Keltsch, der die biologische Spurenanalytik in seiner Doktorarbeit durchführte. Die Gefahr bei der Bekämpfung von Biofilmen mit Bioziden und Antibiotika ist die Resistenzbildung. Dies könnte jedoch durch Beschichtungen von Polymeren mit CeO2-Nanopartikeln wirkungsvoll und umweltfreundlich umgangen werden.
Quelle: idw/Johannes Gutenberg-Universität Mainz
Artikel teilen